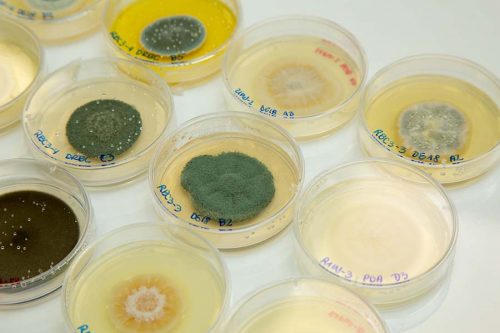

Víctor Gallardo Muñiz, efectuará una estadía de investigación en universidad portuguesa en el marco de una beca del Programa Europeo TNA-MIRRI.
El estudiante de primer año del Doctorado en Ciencias de Recursos Naturales de la Universidad de La Frontera, Víctor Gallardo Muñiz, viajará a Portugal para efectuar una estadía en la Universidad de Minho, como parte de la adjudicación de una beca del Programa Europeo TNA-MIRRI.
Este programa tiene como objetivo apoyar financiera y logísticamente el acceso físico, remoto y virtual de usuarios externos a las instalaciones de investigación de los socios del proyecto europeo IS_MIRRI21 en toda Europa, para llevar a cabo sus proyectos de investigación.
Víctor Gallardo, biotecnólogo de profesión, se integró a trabajar en su ingreso al Programa de Doctorado, a la línea de investigación en biofungicidas naturales creada y liderada por el Dr. Cledir Santos, lo que le permitió desarrollar su propuesta de tesis.
Pie de foto: Cepas de hongos filamentosos aislados desde muestras de suelos antárticos
El proyecto del estudiante Víctor Gallardo tiene como objetivo la búsqueda de lípidos en las membranas celulares de hongos aislados de muestras obtenidas del territorio antártico y el estudio del potencial antifúngico de estos lípidos en contra de hongos patógenos del trigo. La propuesta de investigación es una estrategia mitigadora al uso de antifúngicos sintéticos, que tienen un impacto nocivo al medio ambiente.
La investigación busca aportar al concepto Una Salud (One Health), el que reconoce que la salud de las personas y animales está estrechamente relacionada con la de nuestro medio ambiente; en donde el uso excesivo de antifúngicos sintéticos en el campo puede llevar al surgimiento de resistencia en hongos ambientales. “El surgimiento de hongos resistentes podría traducirse en un problema de salud pública, en un escenario actual en el cual tenemos disponible apenas un conjunto limitado de antifúngicos para el tratamiento de enfermedades de plantas, humanos y animales”, explica Gallardo.
En el marco de adquirir nuevos conocimientos, Gallardo vio la oportunidad de postular a la beca TNA MIRRI en una de las visitas del Dr. Nelson Lima a la Universidad de La Frontera, a la cual postuló con el apoyo del Dr. Cledir Santos y del Programa de Doctorado en Ciencias de Recursos Naturales, adjudicándose esta estadía corta que efectuará en octubre en la Universidad de Minho, donde tendrá la oportunidad de enfocarse a adquirir conocimiento para la identificación de hongos por medio de taxonomía polifásica, incluyendo la biología molecular.
“Desde pregrado me interesaba la investigación, y una de esas áreas era la micología, específicamente la química de hongos, especialidad relacionada con la seguridad e inocuidad alimentaria. Por ello, la realización de esta pasantía significa una oportunidad para ampliar mis conocimientos en la identificación de hongos, con el trabajo que podré desarrollar con el Dr. Nelson Lima”, detalla.
Esta oportunidad, de efectuar estudios en extranjero, cuenta con la colaboración en Chile de la Facultad de Ciencias Agronómicas y de los Alimentos de la Pontificia Universidad de Valparaíso y del INIA-Quilamapu, y, en Europa, de la Infraestructura Europea MIRRI-ERIC, de la Universidad de Minho, de la Universidad de Oporto y del Instituto Politécnico de Oporto.
La propuesta de tesis se enmarca en los proyectos: INACH Regular “Búsqueda de lípidos de hongos antárticos y evaluación de su potencial actividad antifúngica contra hongos patógenos humanos”, del cual es investigador principal el Dr. Cledir Santos, e InES19 FRO19101 “Interacción biotecnología ambiente agricultura para la mitigación del cambio climático: Hacia la sustentabilidad productiva y resiliencia de los recursos naturales”, cuyo director es el Dr. Pablo Cornejo. Además, el estudiante de doctorado cuenta con la colaboración del Dr. Nicolás Cobo (UFRO), Dra. Dalma Castillo y Dr. Iván Matus (INIA-Quilamapu), y del Dr. Nelson Lima (Portugal).
Escrito: Programa Doctorado en Ciencias de Recursos Naturales


